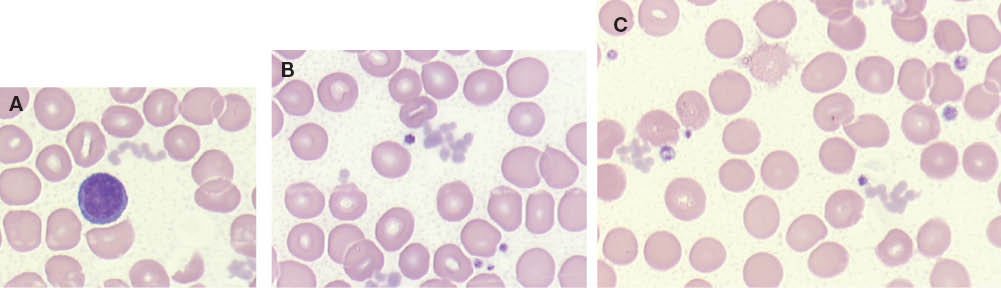

Zusammenfassung
Kryoproteine werden immer noch in hohem Maße unterdiagnostiziert, obwohl sie von besonderer klinischer Relevanz sind. Kryoglobuline, Kryofibrinogen bzw. Kälteantikörper haben eine deutliche Assoziation zu Autoimmunerkrankungen bzw. Non-Hodgkin-Lymphomen. Die Bestimmung ist einfach, aber die präanalytischen Voraussetzungen sind eine Herausforderung. Der Artikel fasst die wesentlichen Aspekte kurz zusammen um diese Situation zu verbessern.
Abstract
Cryoproteins still remain largely undiagnosed despite their clinical relevance. Cryoglobulins, cryofibrinogen and cold agglutinins respectively show a significant association with autoimmune diseases and non-Hodgkin’s lymphoma. The analytical part is relatively straightforward; however, the preanalytical phase is a challenge. This article shortly summarizes the relevant aspects to improve this situation.
Rezensierte Publikation:
Nebe T.
Einleitung
Kryoproteine sind Eiweiße, die unterhalb der Körpertemperatur Präzipitationsphänomene zeigen, die oft eine Krankheit verursachen. Es ist keine automatisierte Analyse auf Knopfdruck auf einem Routinegerät verfügbar und es gibt keinen Diagnostika-Hersteller, der an der Kryoprotein-Diagnostik verdient und dafür Werbung macht. Im Gegenteil führt die geringe Vergütung zu einer Vermeidungsstrategie bei der Untersuchung. Sie werden daher oft nicht oder verspätet erkannt, da die routinemäßige Vorgehensweise bei der Blutentnahme und Analyse der Serumparameter für ihre Entdeckung nicht geeignet ist. Das Verständnis der medizinischen und labortechnischen Hintergründe ist wichtig, damit die am Prozess der Blutentnahme und der Laboruntersuchung beteiligten Personen zusammenarbeiten, um eine vorzeitige Kryopräzipitation zu vermeiden, die Antikörper sichtbar zu machen, damit die richtigen diagnostischen Schlüsse gezogen werden können. Ansonsten treten Verärgerung, gegenseitige Schuldzuweisung und falsche Analysenergebnisse auf. Der organisatorische Aufwand wird durch die diagnostische Aussagekraft gerechtfertigt. Die Belohnung ist der korrekt diagnostizierte Patient, dessen Erkrankung z.T. lange verkannt wurde. Umgekehrt ist der positive Nachweis von Kryoproteinen ein Laborbefund, der zu einer Suche nach den im Nachfolgenden beschriebenen Erkrankungen Anlass geben muss, soweit diese nicht schon bekannt sind. Die tägliche Praxis im Umgang mit Laborpersonal und Einsendern und die auch in unserer Erfahrung viel zu seltene Anforderung [1] haben uns veranlasst, die Sachverhalte rund um Kryoproteine in kompakter Form darzustellen und in Erinnerung zu bringen, obwohl diese in Standardwerken abgehandelt werden [2–4]. Durch verbesserte Technik und Auflösung bei der Immunphänotypisierung ist gerade bei den Kälteantikörpern und Kryofibrinogen eine relativ hohe Assoziation zu Non-Hodgkin Lymphomen entdeckt worden [5, 6].
Begriffsdefinitionen
Die Begrifflichkeiten in diesem Bereich werden oft unscharf verwendet und missverstanden. Zu trennen sind die Begriffe
Kryoglobuline,
Kryofibrinogen(ämie),
Kryopräzipitat und
Kälteagglutinine
Kryoglobuline sind Immunglobuline (Antikörper) im menschlichen Serum, die bei verminderter Temperatur (<37 °C) spontan präzipitieren (Abbildung 1) und bei Erwärmung sich meist wieder auflösen. Diese Präzipitate können im Patienten (in vivo) als auch nach Blutentnahme (in vitro) auftreten. Das Präzipitationsverhalten dieser Eiweiße ist von Patient zu Patient und auch beim Patienten selbst über die Zeit unterschiedlich, abhängig u.a. von Konzentration, Immunglobulinklasse, Aminosäuresequenz, Körpertemperatur, Außentemperatur und pH-Wert. In vivo treten sie naturgemäß häufig in der kälteren Jahreszeit auf und machen sich zum Teil mit schmerzhaften Durchblutungsstörungen an der Haut bemerkbar. Beim M. Waldenström (Immunozytom, Lymphom mit Sekretion von IgM, selten IgG) können die IgM-Antikörper ein Hyperviskositätssyndrom verursachen. Dies kann jedoch auch beim Plasmozytom vorkommen. Kryoglobuline treten bei Erwachsenen gehäuft bei Hepatitis B oder C, bei Autoimmunerkrankungen oder Lymphomen mit Immunglobulin-Sekretion und seltener bei Kindern nach Virusinfektion auf mit oder ohne zusätzliche Kälteantikörper [7].

Kryopräzipitation in Blut und Serum.
Kryofibrinogen ist ein bei Kälte im menschlichen EDTA-Plasma unlöslicher Clot aus Fibrinogen, Fibrin, Fibrinspaltprodukten, Thrombin, Immunglobulinen, Albumin und anderen Proteinen, der sich bei 4 °C bildet und sich bei 37 °C in der Regel wieder auflöst. Kryofibrinogen kann gemeinsam oder unabhängig zu Kryoglobulinen auftreten. Die Unterscheidung zwischen Kryofibrinogen und Kryoglobulinen ist klinisch meist nicht relevant. Kryofibrinogenämie ist die unterdiagnostizierte Vermehrung eines Kryoproteins, welches lebensgefährlich sein kann. Hautnekrosen und thrombotische Ereignisse sind die hauptsächlichen Komplikationen. Kryofibrinogenämie kann in 2 Typen unterteilt werden: Eine primäre (essentielle) und eine sekundäre Form assoziiert mit Autoimmunekrankungen, Malignomen und Sepsis.
Kryopräzipitatbildung in Citrat-antikoaguliertem Plasma ist ein physiologischer und für die industrielle Fraktionierung von Blutplasmaproteinen genutzter Vorgang. Nach Tieffrieren und langsamem Auftauen auf 4 °C von Citratplasma bildet sich ein reversibles Präzipitat, das reich an den für Blutgerinnung wichtigen Proteinen Faktor VIII, von-Willebrand-Faktor und Fibrinogen ist.
Kälte(auto)antikörper sind gegen Erythrozyten gerichtete Immunglobuline, beinahe ausschließlich der Klasse IgM (seltener auch gegen Thrombozyten oder Leukozyten), die zu einer Agglutination der Zellen führen und oft aber nicht immer durch Wärme aufgelöst werden können. Da diese sich spezifisch gegen erythrozytäre Antigene richten und nach erfolgter Antigen-Antikörper-Reaktion in der Regel effektiv Komplement binden und aktivieren, ist die an den Zielzellen durch Komplement verursachte Schädigung bei Erwärmung nicht reversibel und führt in vivo und in vitro zu Zellzerfall (Hämolyse). Sie können gemeinsam oder unabhängig von Kryoglobulinen auftreten. Die Unterscheidung zwischen Kryoglobulinen und Kälteautoantikörpern ist klinisch bedeutsam.
Laborphänomene
Im hämatologischen Labor können (!) Kryoglobuline störend sichtbar werden als kugelförmige Präzipitate, die von den Geräten als Thrombozyten und in Aggregatform (Abbildung 2) als Leukozyten gezählt werden oder das Serum geliert bei Abkühlung. Die Präzipitate müssen nicht kugelförmig sein, sind dann aber charakteristisch. Diese müssen als solche erkannt werden und sind manchmal der erste Hinweis auf das Vorliegen einer Kryoglobulinämie beim Patienten.

(A, B) Zwei Fälle von Kryoglobulinämien mit Störungen der Leukozytenzählung in der Streulichtanalyse am Abbott CellDyn 3500.
Wegweisend ist dabei eine Betrachtung des Ausstrichs. Die Abbildungen 3A–C zeigen die Kryopräzipitate verschiedener Patienten im Ausstrich. Synthetische Immersionsöle können jedoch die Präzipitate wieder auflösen oder undeutlich werden lassen, so dass sie dann dem ungeübten Beobachter entgehen können und zu einem späteren Zeitpunkt nicht mehr sichtbar sind. Bei schlechter Anfärbung muss der Kontrast durch Schließen der Leuchtfeldblende im Mikroskop bzw. der Gamma-Einstellung der Digitalkamera erhöht werden. Die Präzipitate können sowohl die per Impedanzmethode als auch die optisch gemessenen Thrombozytenzahlen erheblich verfälschen. Alternative Methoden wie die Kammerzählung eines Geübten am Mikroskop oder die immunologische Thrombozytenbestimmung mittels eines fluoreszierenden monoklonalen Antikörpers gegen den GpIIb/IIIa-Rezeptor (CD61) erlauben eine korrekte Bestimmung der wahren Konzentration [8].
Mikroskopische Darstellung partikulärer Kryoglobuline mit Störung der Thrombozytenzählung bei drei verschiedenen Patienten.
Wie erkenne ich das Vorliegen einer Störung durch Kryoglobulinämie? Wichtig sind die Beobachtung der Verteilungskurven (Histogramme) am Bildschirm oder auf dem Ausdruck des Hämatologiegerätes, der Vergleich mit Vorwerten (delta-check) und die erneute Messung nach Erwärmung bei 37 °C. Hier gilt, dass sich korrekte hämatologische Werte bei diesen Patienten nur ermitteln lassen, wenn die Probe in einem vorgewärmten Röhrchen (!) abgenommen und warm transportiert wird.
In der Serumanalytik werden die Präzipitate zumeist übersehen, da das Blut zentrifugiert wird und die Präzipitate im Blutkuchen verbleiben. Sie entziehen sich damit auch der Messung (Gesamteiweiß, Immunglobuline, Serumelektrophorese, Immunfixationselektrophorese). Es handelt sich bei den Kryoglobulinen nicht nur um ein störendes Artefakt im Labor, sondern um einen diagnostisch wegweisenden Befund. Bei ordnungsgemäßer Blutentnahme, Transport und Verarbeitung im Labor (Wärmekette bei 37 °C, Serumentstehung im Wärmeschrank >60 min, besser 2 h) kann der Kryokrit gemessen und das Präzipitat analysiert werden (Monoklonalität der Immunglobuline). Es kann sich in einigen Fällen auch um ein Kryofibrinogen handeln (spezifischer Nachweis im EDTA-Blut).
Blutentnahme und Präanalytik
Die korrekte Blutabnahme bei V.a. Kryoproteinämie erfolgt in auf mindestens 37 °C vorgewärmte Blutentnahmesysteme (Serum- und EDTA-Röhrchen und Butterfly im Brutschrank bei 37–39 °C in der Praxis oder Labor über Nacht gelagert) mit Eiltransport im vorgewärmten Behälter ins Labor (im Brutschrank vorgewärmtes Entnahme-System und Thermosbehälter). Undefinierte Warmwasser-Becher, offene Heizkissen etc. sind unbrauchbare Hilfsmittel. Die Zentrifugation muss in einer vorgewärmten Zentrifuge erfolgen, an die sich eine direkte Messung im Gerät anschließt (STAT-Position ohne Wartezeit im Gerät). Nur so ist eine korrekte Analytik möglich. Alternativ kann die warme Zentrifugation bereits in der Praxis erfolgen vor dem Versand in das Labor, wenn die Bedingungen eingehalten werden können.
Daraus wird deutlich, dass der Patient aufgeklärt und extra einbestellt wird, und die Blutentnahme vorbereitet sein muss sowie mehr Zeit erfordert. Das Labor muss vorinformiert sein. Ein Abweichen von den geschilderten Idealbedingungen führt zum Risiko des falsch negativen Befundes. Ein entferntes Einsendelabor ist bei normaler Blutentnahme schwerlich in der Lage, all diese Bedingungen so erfüllen zu können, dass die Ermittlung eines korrekten Ergebnisses gewährleistet werden kann. Es wird sich daher oft anbieten, den Patienten zur Blutentnahme ins Labor zu schicken.
Analytik
Die analytische Abklärung ist an anderer Stelle gut beschrieben [9–11]. Das durchgehend 37 °C warme Serum wird im Labor in ein sog. Kryokrit-Röhrchen überführt (sog. Wintrobe-Röhrchen, s. Abbildung 4, nach Maxwell Wintrobe) und zuerst nach 24 h und dann nach einer Woche Lagerung im Kühlschrank bei 4 °C abgelesen (Skala am Röhrchen). Die Präzipitation kann z.T. lange dauern (s. Tabelle 1). Das Glasröhrchen muss detergenzfrei gespült sein, da Detergenzien (Spülmittel) die Präzipitation verhindern.

Quantifizierung der Kryoglobuline im Kryokrit-Röhrchen nach Wintrobe zur Bestimmung des Kryokrit (sog. Wintrobe-Röhrchen).
Einteilung der Kryoglobulinämien durch die Klassifikation der Kryoglobuline nach Brouet.
Typ I | Typ II | Typ III |
---|---|---|
Monoklonales Immunglobulin meist IgM, IgG, selten IgA oder Bence-Jones-Protein Immunglobuline gleichen Typs lagern direkt aneinander, kein Immunkomplex Vorkommen bei Immunozytom (=M. Waldenström), multiplem Myelom (Plasmozytom) meist hoher Kryokrit Häufigkeit ca. 5–10% Präzipitation meist nach 3–18 h | Gemischte Kryoglobulinämie monoklonales IgM, selten IgA/G + Rheumafaktor-Aktivität, d.h. Polymerisation durch Vernetzung via Anti-Fc-AK (=RF) Vork. bei Autimmunerkrankungen wie Vaskulitiden, Glomerulonephritis, Hauterkrankungen, idiopathischen, lymphoproliferativen Erkrankungen Häufigkeit ca. 50–65% Präzipitation oft nach >72 h | Polyklonale anti-Immunglobuline, meist IgM, bilden mit anderen Ig Immunkomplexe, andere Proteine können mit enthalten sein; Vorkommen bei infektiösen Erkrankungen (Hepatitis C, Bindegewebserkrankungen oder idiopathisch) Häufigkeit ca. 30% Präzipitation oft nach >72 h |
Parallel dazu wird das gleiche Procedere zum Nachweis/Ausschluss von Kryofibrinogen mit einem EDTA-Plasma durchgeführt.
Es wird nach der Ablesung im positiven Falle untersucht, ob sich das vorhandene Präzipitat bei Wiedererwärmung auflöst (bei Kryoglobulinen i.d.R. nicht der Fall). Ein zur Kontrolle immer mitgeführtes Serum einer Normalperson zeigt kein Präzipitat (die Seren dürfen im Kühlschrank nicht gefrieren!).
Das Präzipitat wird dazu dreimal in eiskalter Kochsalzlösung gewaschen und in der Immunfixationselektrophorese unter Zusatz von Lösungsmittel (z.B. 100 μL Fluidil+1 μL β-Mercapto-Ethanol in Abweichung vom normalen Procedere der Immunfixation) untersucht. Dabei werden die Immunglobulinklasse und die ggf. vorhandene Monoklonalität festgestellt. Diese Untersuchung ermöglicht die Kryoglobulinklassifikation, die Hinweise auf die Ursache ergeben kann (s. Tabelle 1).
Eine Arztpraxis kann den ersten Teil des Nachweises von Kryoproteinen auch leicht selbst führen, wenn eine geeignete Zentrifuge mit Temperaturkontrolle verfügbar ist. Die zwingend erforderliche weiterführende Diagnostik muss dann im Speziallabor erfolgen.
Klinik
Kryoglobuline sind Immunglobuline (Antikörper) im menschlichen Serum, die nicht nur einen störenden Laborartefakt darstellen, sondern auch in vivo wirksam sein und Multiorganschäden verursachen können. Zusätzlich zu der von Meltzer beschriebenen Trias von Purpura, Schwäche und Arthralgien finden sich wechselnde Manifestationen an der Haut, Gelenken, Niere, Nervensystem und in der Hämatopoese. Die klinische Behandlung der Patienten bleibt schwierig. Sie konzentriert sich auf die zugrunde liegende lymphoproliferative, infektiöse Erkrankung bzw. systemische Ursache. Sie umfasst Kortikosteroide, andere Immunsuppressiva und Plasmapherese, wobei in letzter Zeit v.a. Rituximab, ein monoklonaler Antikörper gegen B-Zellen, eingesetzt wird, um die B-Zellantwort zu unterbrechen.
Am häufigsten finden sich Kryoglobuline bei monoklonalen Gammopathien, gelegentlich bei chron. Polyarthritis, Glomerulonephritis, Endocarditis lenta, Lues, Malaria, HCV-Infektion, Non-Hodgkin-Lymphomen (s. Tabelle 2). Die Kryoproteine können den Erkrankungen z.T. um Jahre vorausgehen.
Klinische Bilder, die mit einer Kryoglobulinämie verbunden sein könnten.
Infektionen | |
---|---|
Viral: Epstein-Barr Virus, Zytomegalie-Virus (CMV), Hepatitis A-Virus, Hepatitis B-Virus, Hepatitis C-Virus, HIV | |
Bakteriell: Borreliose (Lyme disease), Syphillis, Lepra (Lepromatous leprosy), Q-Fieber, Poststreptokokken-Nephritis, subakute bakterielle Endokarditis | |
Pilze: Coccidioidomycosis | |
Parasitiär: Leishmaniose (Kala-Azar), Toxoplasmose, Echinococcose, Malaria, Schistosomiasis, Trypanosomiasis | |
Hämatologische Erkrankungen | Autoimmune Erkrankungen |
Non-Hodgkin Lymphome | Sjögren-Syndrom |
Hodgkin’s Lymphom | Systemischer Lupus Erythematodus |
Chronisch lymphatische Leukämie | Polyarteriitis nodosa |
Multiples Myelom | Systemische Sklerose |
Chronisch myeloische Leukämie | Rheumatoide Arthritis |
M. Waldenström (Immunozytom) | Autoimmune Thyreoiditis |
Castelman disease | Arteriitis Temporalis |
Myelodysplasie | Dermatomyositis-polymyositis |
Thrombotisch-Thrombozytopenische Purpura | Schönlein-Henoch Erkrankung |
Kälteagglutinin Krankheit | Sarkoidose |
Pulmonäre Fibrose | |
Biliäre Zirrhose | |
Primäres Antiphospholipid Syndrom | |
Entzündliche Darmerkrankungen | |
Endomyokardiale Fibrose | |
Pemphigus vulgaris |
Kryoglobulinämien werden eingeteilt in monoklonale Kryoglobulinämien (=Typ I), wo ein einziger Typ eines monoklonalen Immunoglobulins vorliegt, bei dem es zu einer selbständigen Aneinanderlagerung kommt, während bei gemischten Kryoglobulinämien eine Mischung von entweder einem polyklonalen Immunoglobulin (Ig) G und monoklonalem IgM (Typ II), oder von polyklonalem IgG and polyklonalem IgM (=Typ Ill) vorkommen; beide, monoklonale und polyklonale IgM, haben Rheumafaktor-Aktivität, d.h. durch Bindung des Antikörpers an den FcTeil eines anderen Antikörpers kommt es zu einer Präzipitation.
Die Kryoglobulinämie ist aus mehreren Gründen eine Modellerkankung:
Kryoglobuline können durch einen technisch einfachen Test diagnostiziert werden basierend auf der Laborbeobachtung einer Präzipitation in kaltem Serum,
Organschäden durch Kryoglobulinämie können auf zweierlei Art und Weise verursacht werden: Akkumulation von Kryoglobulinen und autoimmun-vermittelter vaskulitischer Schädigung und
ist die Kryoglobulinämie verbunden mit einem weiten Spektrum an Ätiologien, Symptomen und Endstadien und wird als Erkrankung betrachtet, die Elemente einer autoimmunen und lymphoproliferativen Erkrankung vereint.
Die klinischen Manifestationen ergeben sich entweder aus dem Hyperviskositätssyndrom oder der Vaskulitis kleiner Gefäße. Das Hepatitis C Virus (HCV) ist zwar ein gut bekannter Faktor in der Ätiologie der Kryoglobulinämie, aber es existieren substantielle geografische Unterschiede in der Assoziation zwischen Kryoglobulinen und HCV.
Kryofibrinogenämie
Kryofibrinogen wurde als Kryoprotein erstmals 1955 beschrieben. Seine Prävalenz wird zwischen 0 und 7% geschätzt, bei hospitalisierten Patienten sollen die Werte höher liegen. Systemische Manifestationen sind häufig und neben den Symptomen ähnlich der Kryoglobulinämie kann es zusätzlich zu arteriellen und venösen Thromboembolien kommen. Milde Formen sind reversibel, die Therapie erfolgt mit Kortikosteroiden und Aspirin, bei Thrombosen mit Antikoagulantien [12]. Eine Kryofibrinogenämie kann essentiell sein oder sekundär auftreten im Rahmen von Neoplasien oder Infektionen, Thrombosen oder Kollagenosen mit Vaskulitis. Bei den ca. in 50% der Fälle zunächst als essentiell betrachteten Kryofibrinogenämien konnten in einer Studie im Verlauf der Zeit dann doch zugrundeliegende Lymphome gefunden werden (6 T- und 5 B-Zell-Lymphome) [5], ob nun als Ursache oder Folge, weshalb die Patienten nach Diagnose einer Überwachung bedürfen.
Die essentielle Kryofibrinogenämie stellt ca. 12% aller Kryoproteine dar. Thrombotische Ereignisse sind häufig und sind mit der Menge an Plasma-Kryofibrinogen korreliert. Ein Defekt in der Fibrinolyse kann zu einer Akkumulation von Kryofibrinogen und Gerinnung in kleinen und mittleren Arterien führen. In einem Teil der zunächst als essentiell eingestuften Fälle sind Lymphome ursächlich und sollten daher gezielt gesucht werden
Diagnostische Kriterien für die Essentielle Kryofibrinogenämie (aus: Amdo and Welker [14])
Essentielle Kriterien
typische klinische Präsentation: Plötzlicher Beginn mit Hautveränderungen und konstitutionellen Symptomen mit oder ohne Thrombose, Blutung oder Kälteexposition
Vorhandensein von Kryofibrinogen im Plasma
Abwesenheit von Kryoglobulinen
keine sekundären Ursachen für Kryofibrinogene und keine Anzeichen für andere Gefäßverschlusserkrankungen
Supportive Kriterien
Angiogramm mit abrupter Okklusion von kleinen bis mittleren Arterien
typische Befunde bei Hautbiopsie: Durch Kryofibrinogen verstopfte Gefäße, leukozytoklastische Vaskulitis oder Hautnekrosen
erhöhte Serumspiegel an alpha1-Antitrypsin und alpha2-Makroglobulin
Differentialdiagnosen zur Essentiellen Kryofibrinogenämie (aus: Amdo and Walker [12])
sekundäre Kryofibrinogenämie
Kryoglobulinämie
periphere Gefäßerkrankungen
Erfrierungen (Frostbite)
Thrombotisch thrombozytopenische Purpura (TTP, M. Moschkowiz)
Disseminierte intravasale Gerinnung (DIC)
Coumarin-Nekrose
erbliche Zustände der Hyperkoagulabilität
embolische Erkrankungen wie Endocarditis oder Cholesterol-Embolien
Vaskulitis
Calciphylaxie im Endstadium renaler Erkrankungen
Antiphospholipid-Antikörper Syndrom
Purpura fulminans
Die Häufigkeit der Kryofibrinogenämie am Beispiel einer Studie von Saadoun et al. [6]: In 10 Jahren waren an einer Universitätsklinik 2312 Untersuchungen angefordert worden, von denen 515 positiv waren (22%) bei einem Grenzwert von 50 mg/L zu zwei unterschiedlichen Zeitpunkten. 455 waren dabei mit einer Cryoglobulinämie assoziiert (88%). Von den verbleibenden 60 Fällen einer isolierten Kryofibrinogenämie waren 36 (60%) essentiell und 24 (40%) sekundär.
Kälteantikörper
Kälteantikörper gegen Erythrozyten sind eine Differentialdiagnose der hämolytischen Anämien und werden durch den direkten Coombstest (direkter Antiglobulintest, DAT) in der akuten Hämolyse mit guter Sensitivität erfasst. Im Kindesalter sind sie vorwiegend Infekt-assoziiert, aber auch bei Erwachsenen mit Mycoplasmeninfektion waren in 57% DAT-positiv [15]. Außerdem bilden Kälteautoantikörper das zentrale pathophysiologische Prinzip bei allen Formen der Kälteautoimmunhämolyse und der Kälteagglutininkrankheit, begleitende Kälteautoantikörper bei B-Zell-Lymphomen sind nicht selten, das Screening im direkten Coombstest meist durch C3d-Beladung erkennbar, ist sinnvoll. Diese Assoziation mit B-Zell-Lymphomen, dem eine eigene Entität neben dem Immunozytom zugeschrieben wird [15], führt zu neuen Therapiemöglichkeiten dem CD20-B-Zellantikörper Rituximab mit zusätzlicher Gabe von Fludarabin [15–18]. Auf diese Weise sind Kälteantikörper zu einem Tumormarker geworden.
Zusammenfassung
Kryoproteine werden im Gegensatz zu Hämolyse, Ikterus und Lipämie im Laboralltag kaum systematisch untersucht und sind oft dem Analysespektrum von Blutbanken vorbehalten. Es besteht eine Diskrepanz zwischen der Häufigkeit bei systematischer Suche im Rahmen von Studien und der täglichen Praxis. Jedes Labor sollte daher prüfen, ob es den Test in sein Programm aufnimmt, damit an die Notwendigkeit der Untersuchung erinnert wird z.B. bei der Thromboseabklärung in einer Gerinnungsambulanz, der Hautambulanz oder Rheumasprechstunde. Wenn im Labor der Zufallsbefund eines Kryoproteins oder von Kälteagglutininen erhoben wird, sollte er unbedingt in sichtbarer Weise an den Einsender berichtet werden. Kryoglobuline können trotz Zentrifugation verspätet sichtbar werden (Aufbewahrung von Proben im Kühlraum für Re-Analysen). Es bietet sich eine Durchsicht vor dem Verwerfen der Röhrchen bei Lagerung über 1–2 Wochen an. Im Blutbild und v.a. im Ausstrich müssen auf Kryoproteine geachtet und diese sollten im Befund vermerkt werden. Tabelle 3 fasst das Beschriebene zusammen.
Biochemie und klinische Assoziation von Kryoproteinen.
Begriff | Nachweis | Klinisches Bild | Zusammensetzung | Zusätzliche Untersuchung |
---|---|---|---|---|
Kryoglobuline | Warmes Serum | Ja, typisch | Mono+polyklonale AK, daraus gebildete AK-Ag-Komplexe | Elpho, Immunfixation |
Kryofibrinogenämie | Warmes EDTA-Plasma, warmes Citrat-Plasma | Ja, typisch, ähnlich Kryoglobuline+Thrombose | Mono+polyklonale AK, daraus gebildete AK-Ag-Komplexe mit Fibrinogen, Fibrin, FSP, Thrombin | Elpho, Immunfixation, Gerinnungsteste |
Kälteagglutinine | Warmes Serum, warmes EDTA-Plasma | Leitsymptom Agglutination und Hämolyse+ähnlich Kryoglobuline | Leitsymptome, Hämolyse, Agglutination, mono+polyklonale AK, AK-beladene Erythrozyten als typisches Zielantigen | Immunhäma tologische Teste Elpho, Immunfixation |
Kryopräzipitat | Gefrorenes und dann kontrolliert getautes Citrat-Plasma | Nein, physiologisches Phänomen | Keine AK, keine AK-Ag-Komplexe, nicht gelöstes Fibrinogen, FVIII, vwF, FXIII, Fibronectin und Plättchen-Mikropartikel | Keine |
Interessenkonflikt: Die Autoren erklären, dass keine wirtschaftlichen oder persönlichen Interessenkonflikte bestehen.
Literatur
1. Shihabi ZK. Cryoglobulins: an important but neglected clinical test. Ann Clin Lab Sci 2006;36:395–408.Suche in Google Scholar
2. Thomas L. Labor und Diagnose: Indikation und Bewertung von Laborbefunden für die medizinische Diagnostik, 6th ed. Frankfurt/Main: TH-Books Verlagsgesellschaft mbH, 2005:978–81.Suche in Google Scholar
3. Deutsch E, Geyer G, Wenger R. Laboratoriumsdiagnostik. 3rd ed. Basel: S. Karger Verlag, 1992:840–1.Suche in Google Scholar
4. Keil E, Fiedler H. Klinische Chemie systematisch. 1st ed. Bremen: UNI-MED Verlag AG, 2000:265.Suche in Google Scholar
5. Randen U, Troen G, Tierens A, Steen C, Warsame A, Beiske K, et al. Primary cold agglutinin-associated lymphoproliferative disease: a B-cell lymphoma of the bone marrow distinct from lymphoplasmacytic lymphoma. Haematologica 2014;99: 497–504.10.3324/haematol.2013.091702Suche in Google Scholar PubMed PubMed Central
6. Saadoun D, Elalamy I, Ghillani-Dalbin P, Sene D, Delluc A, Cacoub P. Cryofibrinogenemia: new insights into clinical and pathogenic features. Am J Med 2009;122:1128–35.10.1016/j.amjmed.2009.03.040Suche in Google Scholar PubMed
7. Tedeschi A, Barate C, Minola E, Morra E. Cryoglobulinemia. Blood Rev 2007;21:183–200.10.1016/j.blre.2006.12.002Suche in Google Scholar PubMed
8. von Ahsen N, Ehrlich B, Scott CS, Riggert J, Oellerich M. Cryoglobulins interfere with platelet counts by optical and impedance methods but not with the CD61 immunoplatelet count. Clin Chem 2001;47:1858–60.10.1093/clinchem/47.10.1858Suche in Google Scholar
9. Kallemuchikkal U, Gorevic PD. Evaluation of cryoglobulins. Arch Pathol Lab Med 1999;123:119–25.10.5858/1999-123-0119-EOCSuche in Google Scholar PubMed
10. Thomas L. Labor und Diagnose: Indikation und Bewertung von Laborbefunden für die medizinische Diagnostik, 5th ed. Frankfurt/Main: TH-Books-Verlagsgesellschaft mbH, 1998: 689–99.Suche in Google Scholar
11. Motyckova G, Murali M. Laboratory testing for cryoglobulins. Am J Hematol 2011;86:500–2.10.1002/ajh.22023Suche in Google Scholar PubMed
12. Michaud M, Pourrat J. Cryofibrinogenemia. J Clin Rheumatol 2013;19:142–8.10.1097/RHU.0b013e318289e06eSuche in Google Scholar PubMed
13. Belizna C, Loufrani L, Subra JF, Godin M, Jolly P, Vitecocq O, et al. A 5-year prospective follow-up study in essential cryofibrinogenemia patients. Autoimmun Rev 2011;10:559–62.10.1016/j.autrev.2011.04.009Suche in Google Scholar PubMed
14. Amdo TD, Welker JA. An approach to the diagnosis and treatment of cryofibrinogenemia. Am J Med 2004;116:332–7.10.1016/j.amjmed.2003.09.033Suche in Google Scholar PubMed
15. Ali NJ, Sillis M, Andrews BE, Jenkins PF, Harrison BD. The clinical spectrum and diagnosis of Mycoplasma pneumoniae infection. Q J Med 1986;58:241–51.Suche in Google Scholar
16. Berentsen S. How I manage cold agglutinin disease. Br J Haematol 2011;153:309–17.10.1111/j.1365-2141.2011.08643.xSuche in Google Scholar PubMed
17. Gertz MA. Management of cold haemolytic syndrome. Br J Haematol 2007;138:422–9.10.1111/j.1365-2141.2007.06664.xSuche in Google Scholar PubMed
18. Berentsen S, Beiske K, Tjonnfjord GE. Primary chronic cold agglutinin disease: an update on pathogenesis, clinical features and therapy. Hematology 2007;12:361–70.10.1080/10245330701445392Suche in Google Scholar PubMed PubMed Central
©2014 by De Gruyter
This article is distributed under the terms of the Creative Commons Attribution Non-Commercial License, which permits unrestricted non-commercial use, distribution, and reproduction in any medium, provided the original work is properly cited.
Artikel in diesem Heft
- Frontmatter
- Labormanagement/Laboratory Management
- Empfehlungen zur Häufigkeit der Anforderung von Laboruntersuchungen
- Umfrage zur Laborberatung in Deutschland
- Hämatologie/Hematology
- Bedeutung und Diagnostik von Kryoproteinen
- Hämatologische Labordiagnostik bei Thrombozyten
- Endokrinologie/Endocrinology
- Regional adjustment of thyroid hormone reference intervals
- Buchbesprechung/Book Review
- Furger. Labor quick. Laborwerte und Laborbefunde von A-Z
Artikel in diesem Heft
- Frontmatter
- Labormanagement/Laboratory Management
- Empfehlungen zur Häufigkeit der Anforderung von Laboruntersuchungen
- Umfrage zur Laborberatung in Deutschland
- Hämatologie/Hematology
- Bedeutung und Diagnostik von Kryoproteinen
- Hämatologische Labordiagnostik bei Thrombozyten
- Endokrinologie/Endocrinology
- Regional adjustment of thyroid hormone reference intervals
- Buchbesprechung/Book Review
- Furger. Labor quick. Laborwerte und Laborbefunde von A-Z